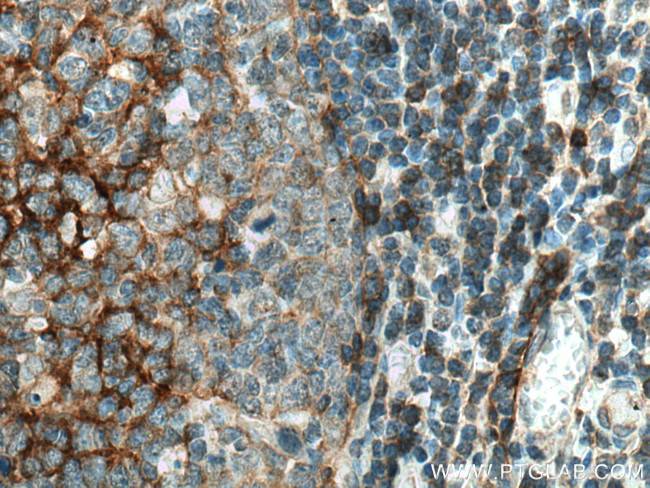
NT5E/CD73 Antibody in Immunohistochemistry (Paraffin) (IHC (P))

Search
Proteintech
NT5E/CD73 Monoclonal Antibody (1G5G8)
{{$productOrderCtrl.translations['antibody.pdp.commerceCard.promotion.promotions']}}
{{$productOrderCtrl.translations['antibody.pdp.commerceCard.promotion.viewpromo']}}
{{$productOrderCtrl.translations['antibody.pdp.commerceCard.promotion.promocode']}}: {{promo.promoCode}} {{promo.promoTitle}} {{promo.promoDescription}}. {{$productOrderCtrl.translations['antibody.pdp.commerceCard.promotion.learnmore']}}
产品信息
67789-1-IG
种属反应
宿主/亚型
分类
类型
克隆号
抗原
偶联物
形式
浓度
规格
纯化类型
保存液
内含物
保存条件
运输条件
产品详细信息
Aliquoting is unnecessary for -20°C storage.
靶标信息
CD73, also known as Ecto-5-prime-nucleotidase or 5-prime-ribonucleotide phosphohydrolase, is an enzyme that catalyzes the conversion of purine 5-prime mononucleotides to nucleosides at neutral pH, with AMP as its preferred substrate. It is composed of a dimer of two identical 70 kDa subunits, externally bound to the plasma membrane via a glycosyl phosphatidyl inositol linkage. CD73 serves as a marker of lymphocyte differentiation and is expressed on a subset of lymphocytes, increasing during lymphocyte maturation. It is found on memory CD4 T cells, which resemble uncommitted primed precursor helper cells (Thpp) capable of differentiating into Th1 or Th2 cells, and is also present on regulatory T cells. CD73 deficiency is associated with various immunodeficiency diseases. Other forms of 5-prime nucleotidase exist in the cytoplasm and lysosomes, distinguishable from CD73 by their substrate affinities, requirement for divalent magnesium ions, activation by ATP, and inhibition by inorganic phosphate. The CD73 gene is localized to chromosome 6q14-q21, and defects in this gene can lead to conditions such as calcification of joints and arteries, and intestinal tuberculosis. Additionally, two transcript variants encoding different isoforms of CD73 have been identified.
仅用于科研。不用于诊断过程。未经明确授权不得转售。
篇参考文献 (0)
生物信息学
蛋白别名: 5'-deoxynucleotidase; 5'-NT; 5'-nucleotidase; CD73; Ecto-5'-nucleotidase; IMP-specific 5'-nucleotidase; Purine 5-Prime-Nucleotidase; Thymidylate 5'-phosphatase; unnamed protein product
基因别名: CALJA; CD73; E5NT; eN; eNT; NT; NT5; NT5E; NTE
UniProt ID: (Human) P21589
Entrez Gene ID: (Human) 4907